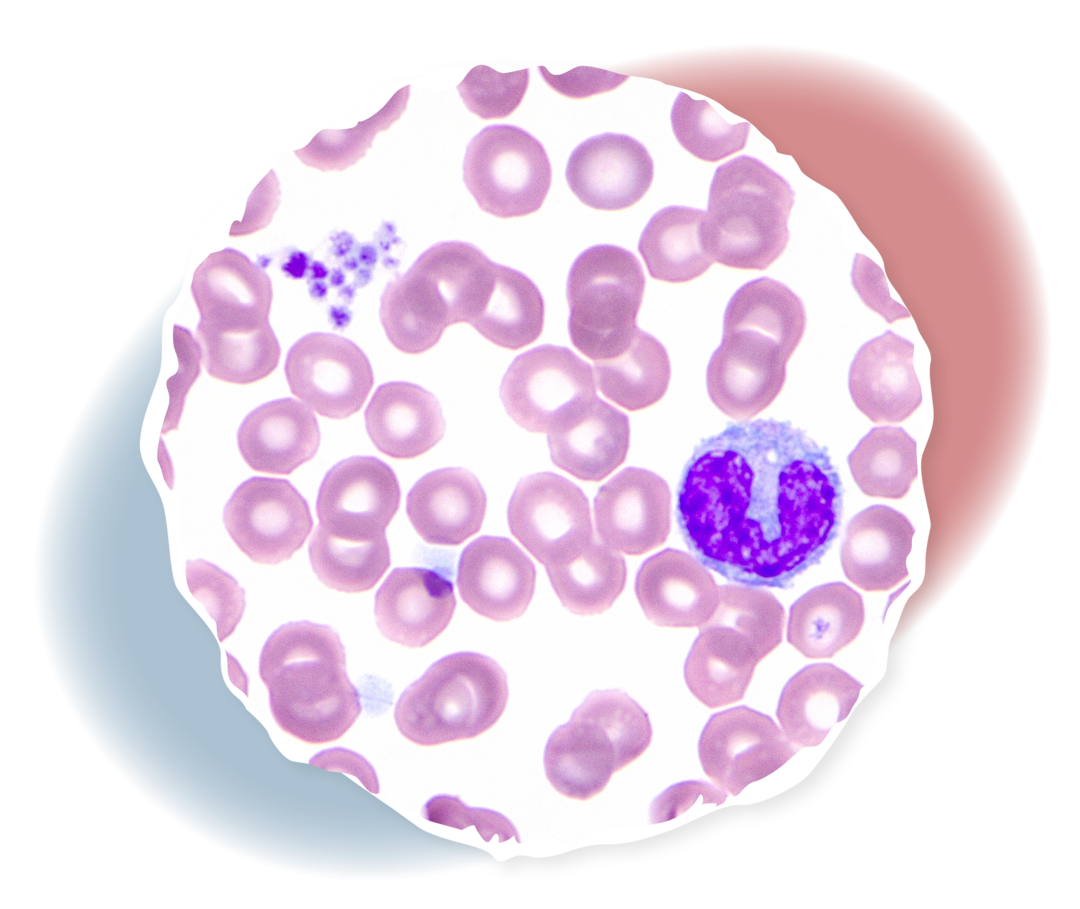

Leiden Sie häufig unter blauen Flecken oder bluten Sie schneller und länger als üblich? Dann besteht möglicherweise der Verdacht auf eine Gerinnungsstörung wie die ITP. Bei Menschen ohne Blutungssymptome wird ein etwaiger Thrombozytenmangel hingegen oft zufällig im Rahmen von Routineuntersuchungen festgestellt. Mit bestimmten Diagnoseverfahren versuchen Ärztinnen und Ärzte, die Ursache zu finden.
Hier erhalten Sie Informationen zu folgenden Themen:

Pixabay https://cdn.pixabay.com/photo/2016/08/10/20/26/stethoscope-1584223__340.jpg
Häufigkeit und Ursachen
Die ITP ist eine seltene Erkrankung, die nicht vererbt wird. Durch eine Fehlfunktion des Immunsystems kommt es zu einem vermehrten Abbau und gleichzeitig einer verringerten Neubildung der Blutplättchen (Thrombozyten). Doch was sind die Ursachen für das plötzliche Auftreten der Erkrankung?

GettyImages-946924788, Westend61
Was passiert bei Verdacht auf eine ITP?
Bei leichten Blutungssymptomen kann die Hausärztin oder der Hausarzt die ersten Untersuchungen durchführen, um eine mögliche Ursache auszumachen. Besteht der Verdacht auf einen Mangel an Thrombozyten (Thrombozytopenie), erfolgt die Überweisung an eine hämatologische Fachpraxis, in der weitere diagnostische Untersuchungen veranlasst werden.
Bevor sich eine gesicherte ITP-Diagnose stellen lässt, sind andere mögliche Auslöser für den Mangel an Blutplättchen auszuschließen. Es gibt keinen spezifischen Labortest, um eine ITP zu nachzuweisen.1
Erhebung der Krankengeschichte (Anamnese)
Im ersten Schritt der Diagnostik erfolgt eine gründliche Erhebung der Krankengeschichte (Anamnese). Dabei werden Sie nach aktuellen und vergangenen Symptomen und Blutungsereignissen gefragt sowie nach möglichen Ursachen. Dazu zählen beispielsweise die Einnahme bestimmter Medikamente, eine Schwangerschaft, Alkoholkonsum oder eine mögliche Erkrankung. Zudem wird Ihre Ärztin oder Ihr Arzt Sie fragen, ob in der Vergangenheit bei Ihnen schon einmal Blutgerinnsel (Thrombosen) aufgetreten sind. Üblicherweise versucht sie oder er zudem in Erfahrung zu bringen, ob bei Ihnen familiäre oder berufliche Stressfaktoren bestehen.

GettyImages-1185256894, TravelCouples
Körperliche Untersuchung
Bei der darauffolgenden körperlichen Untersuchung achtet Ihre Ärztin oder Ihr Arzt auf mögliche Anzeichen von Blutungen sowie Veränderungen der Lymphknoten. Außerdem ertastet sie oder er gegebenenfalls über die Bauchwand eine mögliche Vergrößerung der Milz oder Leber.

Novartis Pharma GmbH
Großes Blutbild
Weisen die Ergebnisse der Anamnese und der körperlichen Untersuchung auf einen möglichen Thrombozytenmangel hin, wird ein großes Blutbild erstellt. Neben der Anzahl der roten und weißen Blutkörperchen (Erythrozyten und Leukozyten) gibt das Blutbild auch Aufschluss über die Konzentration der Thrombozyten (Blutplättchen) im Blut.

GettyImages-1188432159, Maskot
Peripherer Blutausstrich
Wenn sich durch das große Blutbild der Verdacht auf einen Thrombozytenmangel (Thrombozytopenie) erhärtet, wird zusätzlich ein Blutausstrich vorgenommen. Hierzu wird ein Blutstropfen im Labor auf einem Glasträger ausgestrichen, angefärbt und mikroskopisch begutachtet. Anhand des Mikroskopieverfahrens kann eine Hämatologin oder ein Hämatologe womöglich alternative Erkrankungen erkennen beziehungsweise ausschließen.
GettyImages-1168911939, xia yuan
Gerinnungsparameter
Gerinnungstests wie der Quick-Test oder die Bestimmung des Fibrinogenwerts dienen der Überprüfung der Gerinnungsfähigkeit des Blutes und können Anhaltspunkte für mögliche Ursachen des Thrombozytenmangels liefern.
Bei unauffälliger Anamnese und ansonsten normalen Blutwerten kann nach einem mehrfach bestimmten Thrombozytenwert unter 100.000 pro Mikroliter Blut die Diagnose ITP gestellt werden.
Gegebenenfalls wird auch eine Knochenmarkpunktion im Rahmen der Basisdiagnostik durchgeführt.

Novartis Pharma GmbH
Was ist eine Knochenmarkpunktion?
Ziel einer Knochenmarkpunktion ist die Entnahme einer kleinen Menge an Gewebe, um die blutbildenden Zellen im Knochenmark zu untersuchen. Zwar kann die ITP dadurch nicht nachgewiesen werden, allerdings lassen sich alternative Erkrankungen wie beispielsweise eine Leukämie ausschließen. Eine Knochenmarkpunktion wird empfohlen, wenn …
- das Krankheitsbild nicht eindeutig ist und nach erfolgter Basisdiagnostik weiterhin begründete Zweifel an der Diagnose ITP bestehen. Das kann zum Beispiel der Fall sein, wenn nicht nur die Thrombozytenzahlen, sondern auch die Werte der weißen oder roten Blutkörperchen verändert oder Leber oder Lymphknoten vergrößert sind.
- eine Entfernung der Milz (Splenektomie) geplant ist und/oder die Patientin oder der Patient über 60 Jahre alt ist, da mit zunehmendem Alter andere Erkrankungen als Ursache für einen Thrombozytenmangel immer wahrscheinlicher werden.

Novartis Pharma GmbH
Die Knochenmarkpunktion dauert im Normalfall nur wenige Minuten und lässt sich mit örtlicher Betäubung meistens ambulant vornehmen. Mit einer speziellen Nadel werden entweder aus dem Beckenknochen im Bereich des hinteren Beckenkamms oder seltener aus dem Brustbein, wo die Knochen jeweils direkt unter der Haut liegen, etwa fünf bis zehn Milliliter Knochenmark entnommen. Meistens spürt die Patientin oder der Patient nur ein leichtes Druckgefühl an der Punktionsstelle und einen kurzen, stechenden Schmerz, sobald das Knochenmark in die Spritze aufgesaugt wird.2
Die gewonnenen Knochenmarkzellen werden anschließend im Labor auf einen Glasträger ausgestrichen, angefärbt und von einer Fachärztin oder einem Facharzt mikroskopisch begutachtet.4
Der Weg zur Diagnose ITP kann lang und verunsichernd sein
Von den ersten Symptomen bis zur Diagnose ITP ist es für viele Betroffene ein langer Weg. Oftmals müssen Ärztinnen und Ärzte zunächst andere Erkrankungen wie eine Leukämie (Blutkrebs) ausschließen. Diese Ungewissheit kann Angst und Verunsicherung auslösen.
Über ihren ganz persönlichen Weg zur Diagnose und weiteren Erfahrungen mit der Erkrankung erzählen Betroffene hier:
Wenn der Thrombozytenmangel länger andauert, also eine persistierende oder chronische ITP vorliegt, die sich auch mit medikamentösen Maßnahmen nicht in den Griff bekommen lässt, sollten weitere Untersuchungen durchgeführt werden, um andere ursächliche Erkrankungen auszuschließen.
Mögliche zusätzliche Untersuchungen können das Blutserum betreffen, also den flüssigen Bestandteil des Blutes. Darüber hinaus können bildgebende Verfahren wie die Computertomographie (CT) oder die Magnetresonanztomographie (MRT) dabei helfen, bestimmte Tumorerkrankungen auszuschließen. Der Ausschluss bestimmter Infektionskrankheiten wie Hepatitis oder AIDS sowie eine ausgiebige Untersuchung der Schilddrüse können ebenfalls Teil der Diagnostik bei anhaltendem Thrombozytenmangel sein.

Novartis Pharma GmbH
Passende Themen zum Weiterlesen:

iStock-1191193169_alvarez
ITP – Symptome
Die Symptome der ITP können zwischen Betroffenen stark variieren. Erfahren Sie mehr zu den körperlichen Beschwerden und den alltäglichen Einschränkungen durch die ITP.

iStock-1409751960_Moon Safari
ITP – Verlauf und Stadien
Die ITP verläuft in verschiedenen Stadien, die sich auf die Prognose auswirken. Erfahren Sie mehr zu den Krankheitsstadien der Erkrankung.

iStock-1253877186_fizkes
ITP-Patiententage
Schauen Sie sich die Beiträge von Fachleuten und Betroffenen der ITP bei den ITP-Patiententagen 2022 im Video an und erhalten Sie wertvolle Informationen.
Quellen:
- Onkopedia. Leitlinie Immunthrombozytopenie (ITP). https://www.onkopedia.com/de/onkopedia/guidelines/immunthrombozytopenie-itp/@@view/html/index.html (letzter Aufruf am 27.10.2023)
- MPN-Netzwerk e. V. Wie läuft eine Knochenmarkpunktion ab? https://www.mpn-netzwerk.de/mpn-verstehen/knochenmarkpunktion/ (letzter Aufruf am 27.10.2023)
- EBMT. Immunthrombozytopenie – Ein praxisnaher Leitfaden für medizinisches Fachpersonal. https://www.ebmt.org/sites/default/files/migration_legacy_files/document/EBMT%20Practical%20Guides%20for%20Nurses_Immune%20Thrombocytopenia_German.pdf (letzter Aufruf am 27.10.2023)